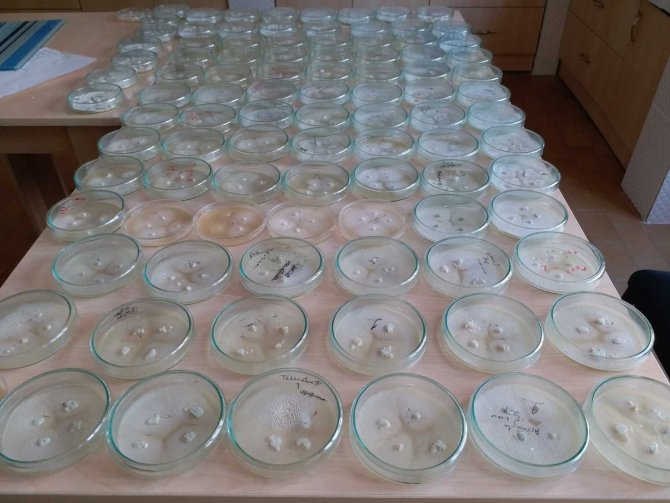
Kestane Ormanlarında Kestane Dal Kanseriyle İlgili Mücadele Devam Ediyor

Kestane Ormanlarında Kestane Dal Kanseriyle İlgili Mücadele Devam Ediyor
Yayınlanma:
Güncelleme:
Artvin Orman Bölge Müdürlüğü bünyesinde Kestane Dal Kanseri ile biyolojik mücadele çalışmaları sürüyor.
Artvin Orman Bölge Müdürlüğü bünyesinde Kestane Dal Kanseri ile biyolojik mücadele çalışmaları sürüyor.
Artvin'de son yıllarda sıkça rastlanan kestane ağacı dal kanseriyle, Orman Bölge Müdürlüğü Laboratuvar biyolojik mücadele sürüyor.
2014 yılından itibaren kestane kanserinin yoğun olduğu sahalardan alınan izolatlara karşı laboratuvar ortamında üretilen virüsler, kanser yaralarının etrafına delik açmak suretiyle veya kanserli yaralara saf su ile karıştırılan hypovirülent virüsü fırça yardımı ile sürülerek uygulanıyor.
Öte yandan kanserin yağmur ve rüzgarlarla yayıldığı tespit edilirken, mücadele çalışmalarının önümüzdeki yıllarda da devam edilmesi planlanıyor.

Kaynak:IHA
Karadeniz